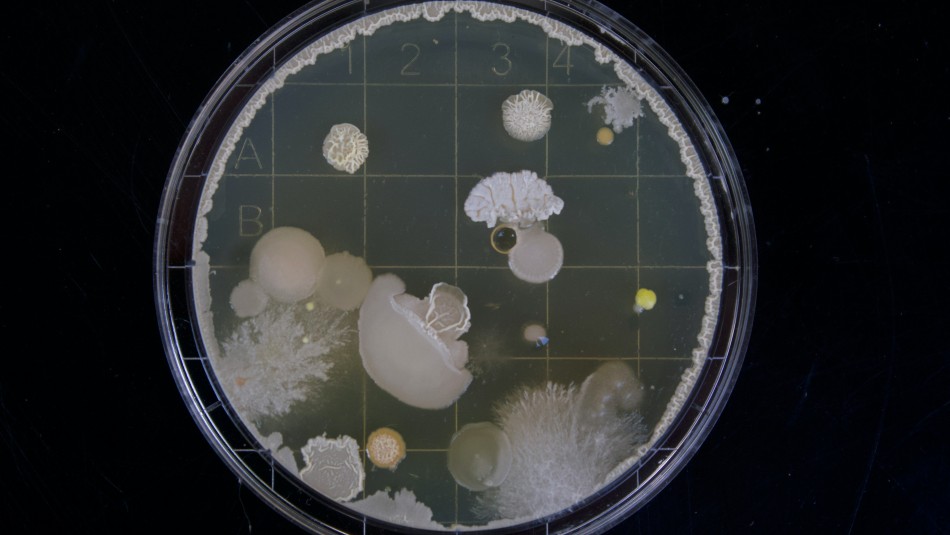

Es malo para tu salud: Esta es la razón por la que jamás deberías usar tu teléfono mientras estás en el baño
Quizás no lo quieres admitir, pero son muchas las personas que utilizan el tiempo que están sentados en el baño para revisar sus redes sociales, ponerse al día con su serie favorita o, ahora, aprovechan para no perderse ningún segundo de los partidos del Mundial de Catar.
Podría parecer un hábito inocuo, pero la verdad es que el uso del celular en el baño podría acarrear una serie de problemas en la salud.



¿Por qué no tengo que llevar el teléfono al baño?

El problema de usar el teléfono es que, probablemente, pierdes la noción del tiempo y te quedas por un periodo más largo de lo necesario.
"Por lo general, no debes pasar más de 10 minutos [sentado], en promedio", explicó sobre el tema el doctor gastroenterólogo, Roshini Raj, a The Washington Post.
Mientras más tiempo pases, más probabilidades tienes de que aparezca una hemorroide, una dolorosa condición con la que se inflaman las venas que rodean el recto y el ano.
"Solo por la posición, la gravedad está haciendo que todo cuelgue, y eso está causando presión en las venas. Así que incluso si no estás pujando, si estás sentado, pensando en otra cosa, haciendo otra cosa, hay algo de presión aplicada a esas venas", detalló el experto al medio estadounidense.
También existe la posibilidad de que por llevar el celular al baño acarrees una serie de gérmenes.
"Veo a gente que se lleva el teléfono al baño todo el tiempo, y los móviles recogen muchos gérmenes", contó a The Healthy, el microbiólogo de la Universidad de Arizona, Charles Gerba.
Según investigaciones previas, tu celular podría acumular 10 veces más bacterias que el asiento del baño, pero si lo tocas sin lavarte las manos o tiras la cadena sin bajar la tapa, la acumulación de microorganismos podría empeorar.
Por último, el vapor y la humedad del baño podrían dañar el dispositivo de manera irreparable.
Nota importante: Este artículo tiene un carácter meramente informativo y por ningún motivo debe reemplazar las indicaciones u órdenes de su médico tratante. Si usted está bajo tratamiento médico o padece de alguna condición crónica, debe seguir estrictamente las recomendaciones de su profesional de salud.
Leer más de